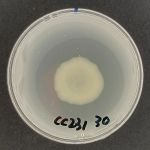
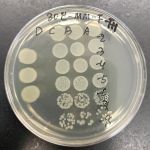

-
About faculty
-
Admissions
-
Study at the Faculty
-
Science and research
-
International relations
-
Contacts
Study at the Faculty
Science and research
International relations
Zátiší 728/II, 389 25 Vodňany Tel. +420 387 774 616 |
Branišovská 1645/31a, 370 05 České BudějoviceTel. +420 387 774 601 |
© University of South Bohemia
Cookies
-
About
-
Contact
-
Laboratory of Freshwater Ecosystems
-
Laboratory of Intensive Aquaculture
-
Laboratory of Reproductive Physiology
-
Laboratory of Molecular, Cellular and Quantitative Genetics
-
Laboratory of Germ Cells
-
Laboratory of Environmental Chemistry and Biochemistry
-
Laboratory of Aquatic Toxicology and Ichthyopathology
-
Genetic Fisheries Center
-
Experimental Fish Culture Facility
-
About the Institute
-
Institute Management
-
Laboratory of controlled reproduction and intensive fish culture
-
Laboratory of Nutrition
-
Laboratory of Machine Vision in Aquaculture and Water Protection
-
Processing Unit and Shop with Fish and Aquaculture Products
1